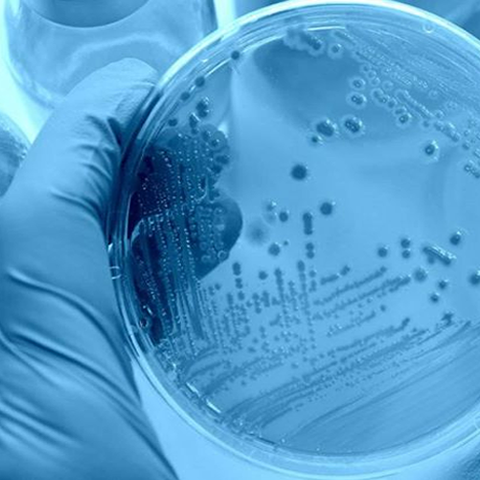

Instituto de Ciencias e Innovación en Medicina (ICIM)
Somos un grupo de investigadores del Instituto de Ciencias e Innovación en Medicina (ICIM) buscamos generar un impacto en los problemas relevantes de salud basada en ciencias, generando evidencia de alta calidad con innovación y tecnología.
Actualmente la aparición y propagación de patógenos farmacorresistentes es cada vez más acelerada a nivel mundial, lo que ha provocado la aparición de infecciones de difícil tratamiento, y por consecuencia un aumento en la mortalidad. Esta situación ha levantado las alarmas en la capacidad que tenemos hoy en día para tratar a las infecciones comunes que han adquirido nuevos mecanismos de resistencia a los antimicrobianos (RAM) y no responden a los medicamentos que comúnmente conocemos como los antibióticos.
Esta realidad ha generado grandes costos para las economías de los países, por lo que la falta de accesos a antimicrobianos de calidad sigue siendo una gran dificultad repercutiendo principalmente en los sistemas de atención en salud debido a las estancias hospitalarias prolongadas de los pacientes, y a la necesidad de una atención más cara e intensiva.
Bajo esta problemática surge la necesidad de crear un grupo de investigación que busque generar un impacto en los problemas relevantes de salud basada en ciencia, un trabajo enmarcado bajo la rigurosidad técnica, con desarrollo de pensamiento crítico para genera evidencia de alta calidad con innovación y tecnología hacia una medicina personalizada y enfocada al beneficio de las personas.
